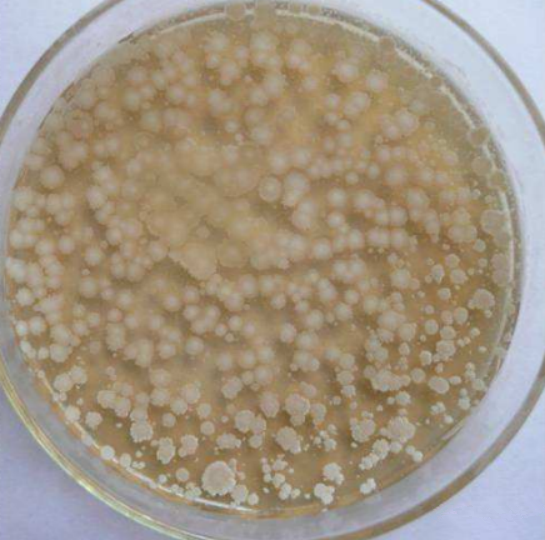
26_副本.png

在日常的园林养护中,对于园林害虫的防治,90%以上都是使用化学药剂进行防控,而对于生物防治因其防治效果慢,防治成本高,认识不足等,目前主要是用于园林市政及森防单位,并且生物防治的目的并不是要彻底消灭害虫,而是要维持生态平衡,把害虫数量控制在较低水平,从而实现“有虫无灾”,利用大自然生物链中“一物降一物”的现象,依靠物种间相互制约的链条关系来达到控制林木有害生物种群数量的目的,对人、畜安全,不会影响人们的正常生活;为增加大家对生物防治的认识,现对生物防治进行一个系统性总结,方便大家参考及应用。
目前用于生物防治的天敌按其灭虫方式不同可分为三类:捕食性天敌、寄生性天敌和昆虫病原微生物。
一、捕食性天敌:指专门以其他昆虫或动物为食物的昆虫。这类天敌直接蚕食虫体的一部分或全部;或者刺入害虫体内吸食害虫体液使其死亡;捕食性天敌昆虫较其寄主猎物一般情况下都大,它们捕获吞噬其肉体或吸食其体液,在发育过程中要捕食许多寄主,而且通常情况下,一种捕食天敌昆虫在其幼虫和成虫阶段都是肉食性,独立自由生活,都以同样的寄主为食。

螳螂属于渐变态昆虫,若虫经8-9龄发育为成虫,通常一年完成一个世代,以卵在卵鞘中越冬;一般5、6月卵孵化,8月上中旬开始出现成虫,成虫一般在9月上中旬开始产卵9月下旬开始死亡,若虫、成虫均为肉食性,若虫成活率低,且有自残现象;成虫也具有自残行为,尤其是在交配的过程中有“妻食夫”的现象,螳螂可捕食40余种害虫,如:蝇、蚊、蝗、蝉、蚜虫、螟类、蛾类、粉虱、蝶类及其幼虫和裸露的蛹。


属昆虫纲,脉翅目,草蛉科,常飞翔于草木间,在树叶上或其它平滑的光洁表面产卵,卵黄色,有丝状长柄,称“优昙华”;幼虫纺锤状,在树叶间捕食蚜虫,故称“蚜狮”;可捕食多种害虫,如:粉虱、红蜘蛛及多种蚜虫等,还可捕食棉铃虫、地老虎、银纹夜蛾、麦蛾和小造桥虫等害虫的卵;常见的有大草蛉、丽草蛉、叶色草蛉、多斑草蛉、粘蛉草蛉、黄褐草蛉、亚非草蛉、白线草蛉、普通草蛉和中华草蛉等,一头草蛉在整个幼虫阶段能吃掉700头以上的蚜虫。


为鞘翅目瓢虫科,幼虫每天游弋在花草之间,疯狂地捕食蚜虫;成年肉食性瓢虫会捕食任何肉质嫩软的昆虫,但最喜欢吃还是蚜虫;瓢虫种类有很多,有捕食性、植食性和菌食性三种,其中以捕食性居多约占80%;植食性次之约占15%;菌食性(以白粉病菌的菌丝和孢子为食),较少约占5%;末龄的瓢虫幼虫每天可捕食大约200头蚜虫;而捕食性瓢虫可捕食蚜虫、介壳虫、粉虱、叶螨、叶蝉、木虱、蓟马等害虫;应用较多的有七星瓢虫、龟纹瓢虫、异色瓢虫、多异瓢虫、大红瓢虫、澳洲瓢虫等。


蝽类属半翅目昆虫,在园林中也有较多种类,有有益蝽类和有害蝽类,其中以花蝽科、盲蝽科、猎蝽科的蝽可捕食叶蝉、飞虱、蚜虫、网蝽、蓟马、叶螨、斜纹夜蛾及棉蛉虫卵等害虫;常见的天敌蝽有蠋蝽、益蝽、叉角厉蝽、小花蝽和红彩瑞猎蝽等。


外观似蜂,卵一般产在蚜群中的为白色,长形,卵壳具网状饰纹,食蚜蝇主要以捕食蚜虫为主,成虫羽化后必须取食花粉才能发育繁殖,否则卵巢不能发育,在化蛹前一只幼虫要吸数百只蚜虫的体液,一般以幼虫或蛹在土中、石下、枯枝落叶下越冬,少数以成虫越冬,除蚜虫外同时也是介壳虫、粉虱、叶蝉、蓟马、鳞翅目小幼虫等的天敌。


捕食螨顾名思义主要以螨虫为食,而不是危害园林植物的螨虫,可捕食红蜘蛛、锈壁虱、二斑叶螨等螨类害虫;捕食性螨类的特点,其生育后代能力很强,不但数量多,而且战斗力很强,常见的有智利螨、钝绥螨、畸螯螨等,一个畸螯螨一生之中可吃红蜘蛛若虫200-500个。
不喜酷热,常隐蔽在石块或树叶下,或营穴居生活,多在夜间出来活动,可捕食粉虱、木虱、叶蝉、螨类、蛾类(卷叶蛾、潜叶蛾)、蝶类等害虫;如:角园蛛、库氏棘腹蛛、棒络新妇、斜纹猫蛛、斑管巢蛛等。


属昆虫类的有翅亚纲革翅目,俗称夹板子,1年发生1代,为杂食性昆虫,常生活在树皮缝隙,枯朽腐木中或落叶堆下,喜潮湿阴暗的环境,雌虫有护卵育幼的特殊习性,有时还会捕捉小虫喂食若虫,直到若虫成长后才离开,主要捕食蛾蝶幼虫、象甲、蚜虫、粉介、蜡蝉若虫等;常见的有日本蠼螋、黄褐蠼螋、蟹蠼螋、红蠼螋等。
二、寄生性天敌:按其寄生部位来说,可分为内寄生和外寄生;内寄生昆虫的幼虫生活于寄主体内,并形成适应于寄主体内生活的特有形态(如表皮构造、呼吸方式、取食及养分吸收的特点等);外寄生昆虫生活于寄主体外,或附着于寄主体上,或在寄主所造成的披盖物内取食,同样也形成适应于体外寄生的特有形态;按被寄生的寄主的发育期来说,可分为卵寄生、幼虫寄生、蛹寄生和成虫寄生,卵寄生昆虫的成虫把卵产入寄主卵内,其幼虫在卵内取食、发育、化蛹,至成虫才咬破寄主卵壳外出自由生活;如赤眼蜂科、缘腹卵蜂科(黑卵蜂)、平腹蜂科、缨小蜂科的大多数种类等;幼虫寄生的昆虫的成虫把卵产入寄主幼虫体内或寄主体外,其幼虫在寄主幼虫体内或体外取食、发育,成熟幼虫在寄主幼虫的体外或体内化蛹,羽化为成虫后自由生活;如小蜂总科的许多种类,姬蜂总科的许多种类,寄蝇、麻蝇的许多种类等;蛹寄生昆虫的成虫把卵产于寄主蛹内或蛹外,其幼虫在寄主蛹内或蛹外取食,在寄主蛹内或蛹外化蛹,成虫期自由生活;如小蜂总科、姬蜂总科、寄蝇、麻蝇的许多种类等属于这个类群;成虫寄生昆虫的成虫把卵产于寄主的成虫体上或体内,其幼虫在寄主体内或附在寄主体上取食、发育,在寄主体内或离开寄主化蛹;如小蜂总科、姬蜂总科、寄蝇、麻蝇等中的一些种属于这个类群。

顾名思义是红眼睛的蜂,不论单眼复眼都是红色的,属于膜翅目赤眼蜂科的一种寄生性昆虫,大多数雌蜂和雄蜂的交配活动是在寄主体内完成的,靠触角上的嗅觉器观寻找寄主,先用触角点触寄主,徘徊片刻爬到其上,用腹部末端的产卵器向寄主体内探钻,把卵产在其中,以老熟幼虫在寄主卵内越冬;可寄生玉米螟、黏虫、条螟、梨小食心虫、棉铃虫、松毛虫、斜纹夜蛾和地老虎等鳞翅目害虫的卵;常见的有松毛虫赤眼蜂、螟黄赤眼蜂、广赤眼蜂、拟澳洲赤眼蜂、稻螟赤眼蜂、亚洲玉米螟赤眼蜂等。

是茧蜂科数百种昆虫的统称,属于膜翅目姬蜂总科的一科,成虫形态与姬蜂极相近,体型一般较小,多数在10mm以下,可用于防治棉铃虫、斜纹夜蛾、粘虫、银纹夜蛾、卷叶螟、梨小食心虫等多种农林害虫的重要天敌;常见的有麦蛾茧蜂、天蛾绒茧蜂、螟蛉绒茧蜂、锈茧蜂、球绒茧蜂、斑痣悬茧蜂等。

与赤眼蜂相似,都寄生于寄主昆虫的卵中,体长1mm以下,可寄生的寄主有飞虱、叶蝉、蚧壳虫、粉虱等;常见的有叶蝉柄翅小蜂、负泥虫缨小蜂、稻虱缨小蜂。

成蝇一般多毛,外表像家蝇,幼虫专门寄生在其它昆虫体内,凡鳞翅目和叶蜂类昆虫的幼虫大都能被寄蝇寄生;如在植物的茎干内生活的天牛、木蠹蛾幼虫,生活在土壤中的金龟子幼虫,还可寄生于甲虫、蝽象等成虫体内。

是姬小蜂科啮小蜂属的一种优势寄生蜂,寄生率高、繁殖力强,成虫体长1mm左右,无蜂针,每个寄生蛹里面装着近5000只周氏啮小蜂,对鳞翅目有害生物“情有独钟”,能将产卵器刺入美国白蛾等害虫蛹内,并在蛹内发育成长,吸尽寄生蛹中全部营养,素有“森林小卫士”之美誉;1年发生7代,以老熟幼虫在美国白蛾蛹内越冬,除寄生美国白蛾外还可寄生在榆毒蛾、柳毒蛾、杨扇周舟蛾、杨小舟蛾、大袋蛾、国槐尺蠖等虫卵体内。
放蜂时间:美国白蛾老熟幼虫期和化蛹初期为最佳放蜂期,放蜂应选择气温25℃以上、晴朗、风力小于3级的天气,10∶00-16∶00之间进行;
投放方式:把即将羽化出蜂的柞蚕茧用皮筋套挂或直接挂在树枝上,或用大头针钉在树干上,让白蛾周氏啮小蜂自然羽化飞出。为防止其它动物侵害,可用树叶覆盖。
投放数量:一个防治区内总放蜂量根据美国白蛾的数量和放蜂方式决定,接种式释放蜂虫比1∶1为宜,淹没式释放蜂虫比3∶1为宜;一般来讲,放置四五个孕育啮小蜂的蚕茧壳,即可消灭掉1亩树林的美国白蛾等害虫,每个蚕茧内可拥有5000头左右的啮小蜂;
投放次数:重点防治区应进行淹没式放蜂防治,再连续进行接种式放蜂防治,预防区应采取连续接种式放蜂防治;1个世代应释放2次蜂,第1次应在美国白蛾老熟幼虫期,第2次宜在第1次放蜂后7-10天(即美国白蛾化蛹初期)进行,也可将白蛾周氏啮小蜂发育期不同蜂蛹混合一次性放蜂。

为肿腿蜂科、硬皮肿腿蜂属的体外寄生蜂,成虫体长2-4mm,无蜂针,不攻击人,以放置装有肿腿蜂的指形管为释放方式,每个指形管装有100只左右的肿腿蜂,是天牛、吉丁等多种蛀干害虫的重要寄生性天敌,雌成虫爬行速度快且钻蛀能力极强,能穿过充满虫粪的虫道寻找到寄主,对于控制蛀干类害虫的危害具有重要作用;以受精雌虫在天牛虫道内群居越冬,翌年4月上中旬出蛰活动,寻找寄主,其寄生活动可分为5个步骤,分别是麻痹寄主,取食发育,清理寄主周围环境,产卵和育幼。
属于膜翅目旋小蜂科平腹小蜂属,主要寄生荔枝蟓卵,还寄生若干种半翅目及鳞翅目卵,吸食蟓卵液,消灭蟓於卵期。


属鞘翅目寄甲科昆虫,可外寄生于如光肩星天牛、松墨天牛、栗山天牛、锈色粒肩天牛、云斑白条天牛、桑天牛等多种蛀干害虫的幼虫和蛹,寄生率达70%-98%;是目前已发现的寄生大型天牛最为有效的天敌昆虫之一,具有寿命长、寄主广和释放期长等3大特点;其操作简便、省工省时、防治效果好、不伤害自然界天敌、不污染环境等优点。
释放时间:在每年4月底至5月初的天牛期(天成虫化之前)或7-8月的天牛幼虫期。
方法用量:释放时选择有新鲜天牛虫粪孔的植株,点株式释放,一般每株被害树上放1管成虫 (6-8 头/管)或 (100 粒/管),具体可根据害虫虫口高低适当增减释放数量。
三、昆虫病原微生物
寄生于昆虫体内引起昆虫发病死亡的细菌,体积微小,一般以分裂繁殖,只有核质而没有真正细胞核的生物;根据昆虫病原细菌的特性和致病所需的条件,可分为专性病原体、产晶体的芽孢细菌、兼性病原体和潜在病原体四类。昆虫被细菌感染后,一般食欲减退,动作乏力,口和肛门上常常带有排泄物;大多数细菌侵入虫体后,先造成感染,最终呈败血症;因细菌而致死的昆虫,体色一般迅速加深,变褐变黑,通常过分软化,使虫体失去原形,内部组织腐烂呈粘性,带有臭味,但虫体干缩后体壁通常仍旧保持原状,与一般因感染某些病毒的液化型死亡症状不同。

是一种子囊菌类的虫生真菌,主要种类包括球孢白僵菌和布氏白僵菌等,常通过无性繁殖生成--分生孢子,菌丝有横隔有分枝,侵入害虫体内,产生白僵素(非核糖体多肽类毒素)、卵孢霉素(苯醌类毒素)和草酸钙结晶,引起昆虫中毒,打乱新陈代谢以致死亡,侵入后4-5天后即死亡,死亡后的虫体白色僵硬,白色粉末状的孢子又可以借助风或昆虫继续散,再次侵染害虫;常见白僵菌共有三种:球孢白僵菌、小球孢白僵菌、布氏白僵菌;依据形态指标、生理生化指标及核酸指标将白僵菌属分为7个种,分别是球孢白僵菌、布氏白僵菌、白色白僵菌、多形白僵菌、蠕孢白僵菌、粘孢白僵菌和苏格兰白僵菌;在生产中主要防治松毛虫、玉米螟、蛴螬、蝗虫、松褐天牛、白蚁、茶小绿叶蝉、桃小食心虫等。


本剂为活体真菌杀虫剂,真菌的形态接近于青霉,菌落绒毛状或棉絮状,最初白色,产生孢子时呈绿色,最后呈暗绿色;通过体表入侵作用进入害虫体内,在害虫体内不断增繁殖通过消耗营养、机械穿透、产生毒素,并不断在害虫种群中传播,使害虫致死。绿僵菌具有一定的专一性,对人畜无害,同时还具有不污染环境、无残留、害虫不会产生抗药性等优点;代表种类有金龟子绿僵菌、罗伯茨绿僵菌和蝗绿僵菌等,不同种类的杀虫范围不同,如金龟子绿僵菌为广谱性杀虫真菌,而蝗绿僵菌只能感染蝗虫等直翅目昆虫。

防虫原理是其菌株可产生内毒素(伴胞晶体)和外毒素两类毒素,使害虫停止取食,最后害虫因饥饿和细胞壁破裂、血液败坏和神经中毒而死亡;而外毒素作用缓慢,在蜕皮和变态时作用明显,这两个时期是RNA合成的高峰期,外毒素能抑制依赖于DNA的RNA聚合酶;该药作用缓慢,害虫取食后2天左右才能见效;可用来防治菜青虫、尺蠖、松毛虫、玉米螟、棉铃虫、卷叶螟、蓑蛾、地老虎等。
来源:植保新声带